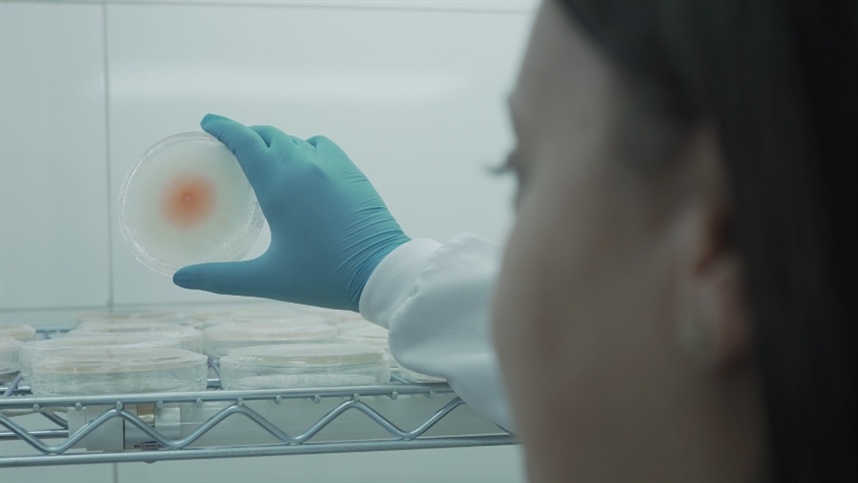

Mercado de insumos biológicos na agricultura é promissor
Tendência de um manejo mais sustentável entre os agricultores tem estimulado crescimento do setor no campo
Foto: Divulgação
Foto: Divulgação
Em cenário promissor tem se estabelecido para o mercado de insumos biológicos na atividade agrícola. Segundo pesquisadores da Embrapa, mais de 130 milhões de doses de inoculantes biológicos foram comercializados no último ano, dos quais cerca de 80% são destinados ao cultivo da soja, milho e trigo, respectivamente.
De acordo com os especialistas, os ganhos de produtividade com o uso dos biológicos pode chegar até 16% na soja. Além disso, os insumos também se mostram favoráveis ao meio ambiente, substituindo os fertilizantes químicos nitrogenados e reduzindo o uso de outros fertilizantes minerais fosfatados.
Atenta a uma tendência de práticas, cada vez mais sustentáveis no campo, a Produce, maior força de vendas diretas do agronegócio brasileiro, acaba de lançar uma linha exclusiva de insumos biológicos. "A chegada dos biológicos ao portfólio da Produce fecha um pacote tecnológico que vai da semente até a colheita. Agora contamos com todo tipo de tecnologia para ajudar o produtor a produzir mais e de forma sustentável", afirma Osmar Cardoso Junior, Gerente de Fertilizantes e Biológicos da Produce.
Para o especialista, o ambiente agrícola está aceitando e buscando cada vez mais os insumos biológicos. "De produtos alternativos, eles estão passando a ser a primeira opção dos agricultores. Por isso, optamos por cepas (bactérias) únicas e exclusivas no mercado, tudo isso para oferecer produtos que tenham alta eficiência e bom custo-benefício", completa.
Outro case de sucesso quando se trata dos benefícios do uso de inoculantes biológicos para os produtores e meio ambiente é a cultura do milho. Recentemente, estudos da Embrapa endossaram a substituição de 25% da adubação nitrogenada de cobertura pela inoculação com Azospirillum brasilense no cultivo.
Com mais de 7 mil consultores espalhados pelo Brasil, a Produce pretende utilizar sua força de vendas para alcançar e atender melhor os pequenos produtores para disponibilizar produtos diferenciados. "O Brasil é reconhecido internacionalmente como o país que mais se beneficia do uso de microrganismos na agricultura. No entanto, suas características continentais dificultam o acesso de muitos produtores a essas tecnologias, mas a partir de agora a Produce vai levar esses produtos até a porteira do agricultor", promete o gerente de fertilizantes da empresa.


